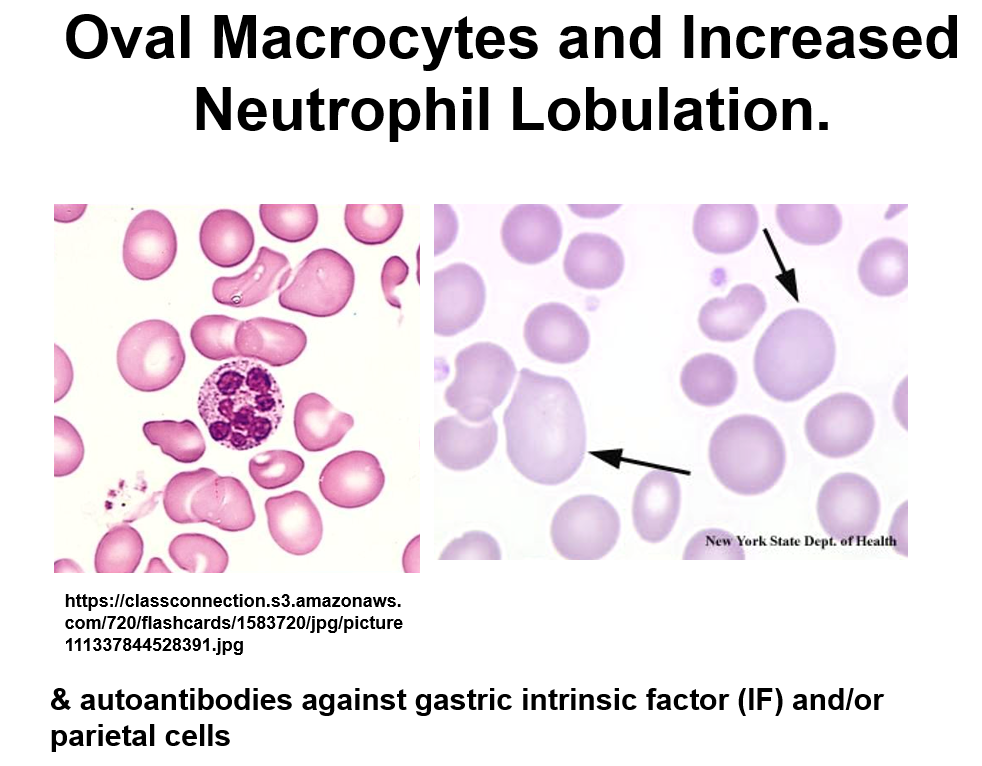

Type II Autoimmune disorder
Damage primarily mediated by autoantibodies against host cell surfaces or extracellular matrix; activates complement or acts as receptor agonist/antagonist.
Type III Autoimmune disorder
Damage primarily mediated by autoantibodies against soluble intracellular antigens or serum antigens
immune complex deposition, complement activation, and inflammation.
Type IV Autoimmune disorder
Damage primarily mediated by auto-reactive effector T cells.
What are receptor agonist and antagonist autoantibodies?
Agonist: Stimulate receptor function upon binding (e.g., Graves’ disease).
Antagonist: Inhibit receptor function upon binding (e.g., autoimmune pernicious anemia).
Genetic factors involved in autoimmunity?
Polymorphisms in genes related to tolerance induction and T cell activation/regulation (MHC genes, cytokine/cytokine receptor genes, BCR and TCR genes, complement genes, etc.).
Specific examples include AIRE, FoxP3, Fas, and HLA/MHC haplotypes.
AIRE’s role in autoimmunity
AIRE is a transcription factor that induces the expression of tissue-specific proteins in the thymus. Defects lead to escape of self-reactive T cells from negative selection (APECED).
FoxP3’s role in autoimmunity
FoxP3 is a transcription factor required for Treg cell development. Defects can cause immune dysregulation (IPEX).
Role of Fas and FasL in autoimmunity
Fas and FasL mediate apoptosis of self-reactive T cells. Defects lead to autoimmune lymphoproliferative syndrome (ALPS)
How does MHC variability affect autoimmunity?
Certain MHC allotypes present some self-antigens more efficiently, increasing the risk of an immune response (e.g., HLA-B27 and ankylosing spondylitis)
How do trauma and infection induce autoimmunity?
Trauma can release hidden self-antigens. Infections can activate APCs to present self-antigens, leading to self-reactive T cell activation (molecular mimicry and epitope spreading). Examples include rheumatic fever and reactive arthritis.
epitope spreading
Autoimmune response broadens over time to include additional self-antigens.
What are some examples of Type II autoimmune disorders?
Immune/autoimmune thrombocytopenic purpura (ITP or ATP), heparin-induced thrombocytopenia (HIT), acquired autoimmune hemophilia.
What is ITP/ATP?
Autoantibodies against platelet cell surface molecules (e.g., GPIIb/IIIa) lead to platelet destruction, causing thrombocytopenia, purpura, and petechiae.

If HIV status is unknown - test
ITP also presents w/ SLE
What is HIT?
Autoantibodies against heparin-PF4 complexes trigger platelet activation and destruction, leading to thrombocytopenia and thrombosis.

Heparin inhibits ATIII (ATIII inhibits factor Xa)
What is acquired autoimmune hemophilia?
Autoantibodies against coagulation factor VIII inhibit clotting, leading to prolonged bleeding times. Symptoms include spontaneous hematomas and hemarthrosis. Diagnosis involves prolonged aPTT and a mixing study showing factor VIII deficiency.

Inhibits intrinsic pathway
What is autoimmune hemolytic anemia (AIHA)?
Autoantibodies against RBCs leading to RBC destruction (intravascular or extravascular hemolysis). Types include warm (IgG) and cold (IgM) AIHA, each with distinct clinical presentations and diagnostic tests (Direct Coombs test).

What is autoimmune pure red cell aplasia?
Autoimmune destruction of erythroid precursors, leading to severe anemia with normal WBC and platelet counts. Diagnosis involves low reticulocyte count and bone marrow examination showing absence of erythroblasts.

RBCs that reach maturity are normal
What is autoimmune pernicious anemia (PA)?
Autoantibodies against intrinsic factor or parietal cells impair vitamin B12 absorption, leading to macrocytic anemia and neurological symptoms. Diagnosis involves detection of anti-IF and anti-parietal cell antibodies and low B12 levels.
What is systemic lupus erythematosus (SLE)?
Type III autoimmune disorder characterized by autoantibodies against nuclear and cytoplasmic antigens. Immune complex deposition in various tissues causes inflammation and organ damage. Diagnosis involves testing for antinuclear antibodies (ANA) and anti-dsDNA antibodies.

What is acquired aplastic anemia?
Severe bone marrow failure due to destruction of hematopoietic stem cells. Possible causes include self-reactive T cells and stem cell defects.
Symptoms include pancytopenia (anemia, neutropenia, thrombocytopenia) and bone marrow biopsy reveals hypocellular marrow.

What is celiac disease?
Type IV hypersensitivity to gluten peptides leading to small intestinal inflammation (villous atrophy) and malabsorption
Diagnosis involves serologic testing for anti-tissue transglutaminase antibodies
HLA-DQ2/DQ8 typing
What is Crohn’s disease?
Chronic inflammatory bowel disease believed to be caused by dysregulation of immune responses to gut microbiota. Symptoms include diarrhea, abdominal pain, weight loss, and extraintestinal manifestations. Diagnosis involves endoscopy, imaging, and serologic testing.
Describe Plasmaphoresis
It removes circulating autoantibodies and cytokines
A procedure where plasma is removed from the blood, purified cells are combined with donor plasma or saline, and the mixture is returned to the patient.
Describe IVIG
Intravenous immunoglobulin; high doses of non-autoreactive IgG may prevent autoantibody/self-antigen complex formation and reduce inflammation.







